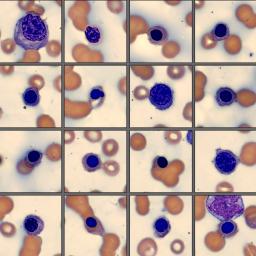

Monthly Cell Challenge #10 / 2025: Swirling cells
A 67-year-old gentleman went to his general practitioner for a check-up because of weight-loss and swollen lymph nodes. The patient also had a history of rash and hair loss.
#9 / 2025: The Case of Conflicting Clues
A 68-year-old woman presented to the emergency department with complaints of back and hip pain, progressive weight loss, shortness of breath, fever, generalized weakness, nausea, and vomiting.
#8 / 2025: Hidden in the Smear!
A 7-year-old spayed female German Shepard came to the vet clinic after the owners noticed a few days of reduced general condition, fatigue, loss of appetite and labored breathing. The veterinarian ordered a CBC and differential.
#7 / 2025: Darling, I see you…
A 54-year-old female came to the ER with fever, nausea, vomiting and diarrhea, abdominal pain, shortness of breath, weakness, and loss of weight and appetite. She also had severe sinus congestion, edema, and enlarged spleen and liver.
#6 / 2025: Blast attack
A 58-year-old male presented to the emergency room with fever, weakness, abdominal pain, enlarged lymph nodes, enlarged spleen, shortness of breath and loss of appetite.
#5 / 2025: Lymphocyte explosion
A 78-year-old man went for his yearly check-up at his general physician. Lately, he had some trouble with tiredness and recurrent infections but had not thought much about it.
#4 / 2025: 2-year-old with large blast-like cells
A 2-year-old girl went to a pediatrician with her parents because of unexplained fever, fatigue, weakness, weight loss and shortness of breath.
#3 / 2025: Furry Friend with coughing
A 6-year-old dog, adopted from a shelter in Spain, arrives with its owner to their local veterinarian in Germany because of fatigue, weight-loss, and coughing.
#2 / 2025: Child with atypical white blood cell granulation
A 9-year-old female presented to the pediatric emergency room with fever, weakness, bone pain, enlarged lymph nodes, shortness of breath and loss of appetite.
#1 / 2025: Child with lymphoblast on peripheral blood
A 9-year-old female presented to the pediatric emergency room with fever, weakness, bone pain, enlarged lymph nodes, shortness of breath and loss of appetite.
Monthly Cell Challenges from 2024
74-year-old male presented to the emergency department with weakness, shortness of breath, abdominal pain, and unexplained bruising.
A 47-year-old male with cough, fever, unexpected weight loss, pain, and generalized lymphadenopathy was seen by his primary caregiver. Routine labs were ordered.

4-year-old girl with fever, stuffy nose, inflamed tonsils with white spots, and swollen lymph nodes was seen by her pediatrician. A Monospot test was negative.
